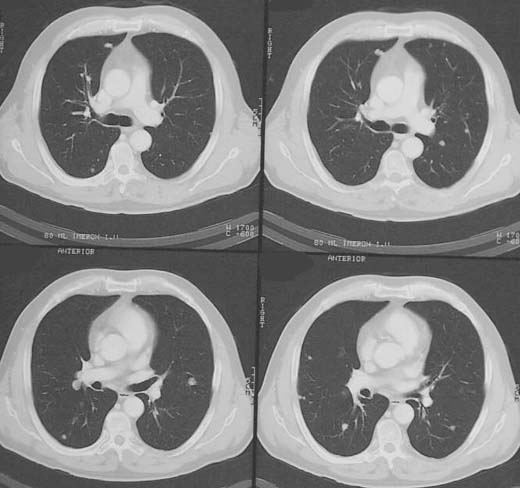

ANAMNESE
/ KLINIK:
Patient, 53, Z. n. Rektumamputation bei Rektum-Karzinom.
BEFUND:
Im
Lungenfenster multiple weichteildichte
Rundherde in mehreren Lungensegmenten.
DIAGNOSE:
Multiple Lungenmetastasen bei Rectum-Karzinom
Informationen
aus dem Internet:
1) Jend
2) Uni Marburg
3) Chorus
4) Learning radiology




